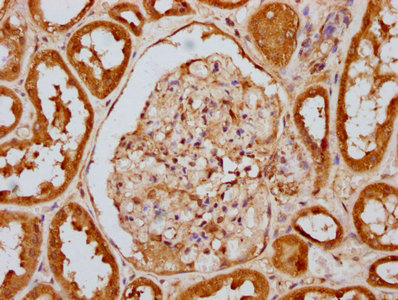

Phospho-EIF2AK2 (T446) Recombinant Monoclonal Antibody
-
中文名稱(chēng):磷酸化-EIF2AK2 (T446)重組抗體
-
貨號(hào):CSB-RA007511A446phHU
-
規(guī)格:¥1320
-
圖片:
-
Western Blot
Positive WB detected in Hela whole cell lysate(treated with Calyculin A or not)
All lanes Phospho-EIF2AK2 antibody at 1.25μg/ml
Secondary
Goat polyclonal to rabbit IgG at 1/50000 dilution
Predicted band size: 62 KDa
Observed band size: 62 KDa -
IHC image of CSB-RA007511A446phHU diluted at 1:100 and staining in paraffin-embedded human kidney tissue performed on a Leica BondTM system. After dewaxing and hydration, antigen retrieval was mediated by high pressure in a citrate buffer (pH 6.0). Section was blocked with 10% normal goat serum 30min at RT. Then primary antibody (1% BSA) was incubated at 4℃ overnight. The primary is detected by a biotinylated secondary antibody and visualized using an HRP conjugated SP system.
-
Immunofluorescence staining of Hela cells(treated with 50mM Calyculin A for 30min) with CSB-RA007511A446phHU at 1:100,counter-stained with DAPI. The cells were fixed in 4% formaldehyde, permeabilized using 0.2% Triton X-100 and blocked in 10% normal Goat Serum. The cells were then incubated with the antibody overnight at 4℃. The secondary antibody was Alexa Fluor 488-congugated AffiniPure Goat Anti-Rabbit IgG (H+L).
-
-
其他:
產(chǎn)品詳情
-
產(chǎn)品描述:Phospho-EIF2AK2 (T446) Recombinant Monoclonal Antibody(CSB-RA007511A446phHU)是一種高特異性抗體,靶向真核翻譯起始因子2α激酶2(EIF2AK2,又稱(chēng)PKR)在Thr446位點(diǎn)的磷酸化修飾。EIF2AK2是一種干擾素誘導(dǎo)的雙鏈RNA依賴(lài)蛋白激酶,在抗病毒免疫、細(xì)胞應(yīng)激響應(yīng)及翻譯調(diào)控中發(fā)揮關(guān)鍵作用,其Thr446磷酸化與激酶活化及下游信號(hào)通路(如eIF2α磷酸化介導(dǎo)的翻譯抑制)密切相關(guān)。該抗體經(jīng)嚴(yán)格驗(yàn)證,適用于ELISA、Western Blot(WB)、免疫組織化學(xué)(IHC)和免疫熒光(IF)等多種實(shí)驗(yàn),推薦稀釋比例為WB 1:500-1:5000、IHC 1:50-1:200、IF 1:20-1:200,展現(xiàn)出優(yōu)異的靈敏度和特異性,可清晰檢測(cè)內(nèi)源性磷酸化EIF2AK2蛋白。其應(yīng)用場(chǎng)景涵蓋病毒感染機(jī)制研究、細(xì)胞應(yīng)激應(yīng)答調(diào)控分析、蛋白質(zhì)翻譯抑制通路探索,以及與神經(jīng)退行性疾病或腫瘤發(fā)生相關(guān)的分子機(jī)制研究,為科研人員提供可靠工具用于探索EIF2AK2在疾病模型或信號(hào)網(wǎng)絡(luò)中的功能及調(diào)控機(jī)制。
-
Uniprot No.:
-
基因名:
-
別名:Double stranded RNA activated protein kinase antibody; E2AK2_HUMAN antibody; eIF-2A protein kinase 2 antibody; EIF2AK1 antibody; EIF2AK2 antibody; Eukaryotic translation initiation factor 2 alpha kinase 2 antibody; Eukaryotic translation initiation factor 2-alpha kinase 2 antibody; HGNC:9437 antibody; Interferon induced double stranded RNA activated protein kinase antibody; Interferon inducible elF2 alpha kinase antibody; Interferon inducible RNA dependent protein kinase antibody; Interferon-induced; double-stranded RNA-activated protein kinase antibody; Interferon-inducible RNA-dependent protein kinase antibody; MGC126524 antibody; P1/eIF-2A protein kinase antibody; P1/eIF2A protein kinase antibody; p68 kinase antibody; PKR antibody; PPP1R83 antibody; PRKR antibody; Protein kinase interferon inducible double stranded RNA dependent antibody; Protein kinase RNA activated antibody; Protein kinase RNA-activated antibody; Protein phosphatase 1 regulatory subunit 83 antibody; Serine/threonine protein kinase TIK antibody; Tyrosine protein kinase EIF2AK2 antibody
-
反應(yīng)種屬:Human
-
免疫原:A synthesized peptide derived from Human Phospho-EIF2AK2 (T446)
-
免疫原種屬:Homo sapiens (Human)
-
標(biāo)記方式:Non-conjugated
-
克隆類(lèi)型:Monoclonal
-
抗體亞型:Rabbit IgG
-
純化方式:Affinity-chromatography
-
克隆號(hào):2F8
-
濃度:It differs from different batches. Please contact us to confirm it.
-
保存緩沖液:Rabbit IgG in 10mM phosphate buffered saline , pH 7.4, 150mM sodium chloride, 0.05% BSA, 0.02% sodium azide and 50% glycerol.
-
產(chǎn)品提供形式:Liquid
-
應(yīng)用范圍:ELISA, WB, IHC, IF
-
推薦稀釋比:
Application Recommended Dilution WB 1:500-1:5000 IHC 1:50-1:200 IF 1:20-1:200 -
Protocols:
-
儲(chǔ)存條件:Upon receipt, store at -20°C or -80°C. Avoid repeated freeze.
-
貨期:Basically, we can dispatch the products out in 1-3 working days after receiving your orders. Delivery time maybe differs from different purchasing way or location, please kindly consult your local distributors for specific delivery time.
-
用途:For Research Use Only. Not for use in diagnostic or therapeutic procedures.
相關(guān)產(chǎn)品
靶點(diǎn)詳情
-
功能:IFN-induced dsRNA-dependent serine/threonine-protein kinase that phosphorylates the alpha subunit of eukaryotic translation initiation factor 2 (EIF2S1/eIF-2-alpha) and plays a key role in the innate immune response to viral infection. Inhibits viral replication via the integrated stress response (ISR): EIF2S1/eIF-2-alpha phosphorylation in response to viral infection converts EIF2S1/eIF-2-alpha in a global protein synthesis inhibitor, resulting to a shutdown of cellular and viral protein synthesis, while concomitantly initiating the preferential translation of ISR-specific mRNAs, such as the transcriptional activator ATF4. Exerts its antiviral activity on a wide range of DNA and RNA viruses including hepatitis C virus (HCV), hepatitis B virus (HBV), measles virus (MV) and herpes simplex virus 1 (HHV-1). Also involved in the regulation of signal transduction, apoptosis, cell proliferation and differentiation: phosphorylates other substrates including p53/TP53, PPP2R5A, DHX9, ILF3, IRS1 and the HHV-1 viral protein US11. In addition to serine/threonine-protein kinase activity, also has tyrosine-protein kinase activity and phosphorylates CDK1 at 'Tyr-4' upon DNA damage, facilitating its ubiquitination and proteosomal degradation. Either as an adapter protein and/or via its kinase activity, can regulate various signaling pathways (p38 MAP kinase, NF-kappa-B and insulin signaling pathways) and transcription factors (JUN, STAT1, STAT3, IRF1, ATF3) involved in the expression of genes encoding proinflammatory cytokines and IFNs. Activates the NF-kappa-B pathway via interaction with IKBKB and TRAF family of proteins and activates the p38 MAP kinase pathway via interaction with MAP2K6. Can act as both a positive and negative regulator of the insulin signaling pathway (ISP). Negatively regulates ISP by inducing the inhibitory phosphorylation of insulin receptor substrate 1 (IRS1) at 'Ser-312' and positively regulates ISP via phosphorylation of PPP2R5A which activates FOXO1, which in turn up-regulates the expression of insulin receptor substrate 2 (IRS2). Can regulate NLRP3 inflammasome assembly and the activation of NLRP3, NLRP1, AIM2 and NLRC4 inflammasomes. Plays a role in the regulation of the cytoskeleton by binding to gelsolin (GSN), sequestering the protein in an inactive conformation away from actin.
-
基因功能參考文獻(xiàn):
- We demonstrated the activation of PKR pathway in CADASIL PMID: 30073405
- These results establish that PKR regulation through stress-induced TRBP phosphorylation is an important mechanism ensuring cellular recovery and preventing apoptosis due to sustained PKR activation. PMID: 29348664
- Auto-phosphorylation represses PKR activity. PMID: 28281686
- The finding that zebularine upregulates CYP gene expression through DNMT1 and PKR modulation sheds light on the mechanisms controlling hepatocyte function and thus may aid in the development of new in-vitro systems using high-functioning hepatocytes PMID: 28112215
- Multiples studies identified PKR as a crucial component of the host defense mechanism against viruses. The dynamic nature of PKR's structure allows it to interact with viral and many cellular molecules that ultimately affect the function of target molecules and downstream components of their pathways. [review] PMID: 29716441
- High PKR expression is associated with Colorectal Cancer Cell Invasiveness. PMID: 30275201
- The data demonstrate that E3 promotes F1 expression by blocking activation of the double-stranded RNA-activated protein kinase R (PKR). PMID: 29997208
- findings indicate that MSI1 plays a leading role in stress granule formation that grants cancer stem cell properties and chemoresistant stress granules in GBM, in response to stressful conditions via the PKR/eIF2alpha signalling cascade. PMID: 29486283
- Here, the authors report that LRP16 selectively interacts and activates double-stranded RNA-dependent kinase (PKR), and also acts as scaffolds to assist the formation of a ternary complex of PKR and IKKbeta, prolonging the polymers of ADP-ribose (PAR)-dependent nuclear factor kappa B (NF-kappaB) transactivation caused by DNA-damaging agents and confers acquired chemoresistance. PMID: 28820388
- These data suggest that even a modest increase in expression of this weak PKR antagonist is sufficient to enable RhCMV replication in human cells. PMID: 29263260
- Activation of PKR by TNF-alpha mRNA element enables PKR phosphorylation. PKR phosphorylation on Ser51 is necessary and sufficient for efficient splicing of TNF-alpha mRNA. PMID: 28683312
- PKR is co-opted by EV-A71 via viral protease 3C-mediated proteolytic activation to facilitate viral replication. PMID: 28702377
- Findings suggest a novel role for PKR in lung cancer cells as a mediator of radiation resistance possibly through translocation of the protein product to the nucleus. PMID: 27203671
- a novel, positive role for PKR activation and eIF2alpha phosphorylation in human globin mRNA splicing, is reported. PMID: 28374749
- Clustered regularly interspaced short palindromic repeat (CRISPR)/Cas9-mediated ablation of double-stranded RNA (dsRNA)-activated protein kinase R (PKR) restored p53 responses while boosting hepatitis C virus replication, showing that p53 inhibition results directly from viral activation of PKR. PMID: 28442604
- Gene silencing studies showed that the suppression of immunoproteasome induction is essentially dependent on protein kinase R (PKR). Indeed, the generation of a strictly immunoproteasome-dependent cytotoxic T lymphocyte epitope was impaired in in vitro processing experiments using isolated 20S proteasomes from HCV-infected cells and was restored by the silencing of PKR expression. PMID: 27833096
- data provide the first evidence that KSHV ORF57 plays a role in modulating PKR/eIF2alpha/SG axis and enhances virus production during virus lytic infection. PMID: 29084250
- The PKR is a key constituent of the metaflammasome and interacts directly with several inflammatory kinases, such as inhibitor kappaB (IkappaB) kinase (IKK) and c-Jun N-terminal kinase (JNK), insulin receptor substrate 1 (IRS1), and component of the translational machinery such as eIF2alpha. PMID: 26831644
- infection with New World arenaviruses JUNV and MACV, but not OW LASV, activated PKR, concomitant with elevated phosphorylation of the translation initiation factor alpha subunit of eukaryotic initiation factor 2 PMID: 28794024
- The stem-loop of noncoding RNA 886 is structural feature not only critical for inhibiting PKR autophosphorylation, but also the phosphorylation of its cellular substrate, EIF-2alpha. PMID: 28069888
- Protein kinase R (PKR) was required for induction of stress granules (SGs) by mumps virus (MuV) infection and regulated type III IFN (IFN-lambda1) mRNA stability. PMID: 27560627
- data establish a model in which the Influenza A virus NS1 N-terminal domain engages in a binding interaction to inhibit activation of PKR and ensure efficient viral propagation and virulence PMID: 28250123
- It was established in this report that interactions between PACT, ADAR1 and HIV-1-encoded Tat protein diminish the activation of PKR in response to HIV-1 infection. PMID: 28167698
- In insulitic islets from living patients with recent-onset T1D, most of the overexpressed ISGs, including GBP1, TLR3, OAS1, EIF2AK2, HLA-E, IFI6, and STAT1, showed higher expression in the islet core compared with the peri-islet area containing the surrounding immune cells PMID: 27422384
- NF90 exerts its antiviral activity by antagonizing the inhibitory role of NS1 on PKR phosphorylation PMID: 27423063
- Crucially, Chlamydia trachomatis infection resulted in robust IRE1alpha RNAse activity that was dependent on TLR4 signalling and inhibition of IRE1alpha RNAse activity prevented PKR activation. PMID: 27021640
- the expression of a Tat construct containing mutations in the basic region (49-57aa), which is responsible for the interaction with PKR, favored neither parasite growth nor IL-10 expression in infected macrophages. PMID: 26608746
- This study provides insight into the molecular pathology of Cornelia de Lange syndrome by establishing a relationship between NIPBL and HDAC8 mutations and PKR activation. PMID: 26725122
- The Newcastle disease virus-induced translation shutoff at late infection times was attributed to sustaining phosphorylation of eIF2a, which is mediated by continual activation of PKR and degradation of PP1. PMID: 26869028
- The sole essential function of cytomegalovirus TRS1 is to antagonize host PKR. PMID: 26716879
- results show that ceramide acts at two distinct levels of the insulin signaling pathway (IRS1 and Akt). PKR, which is induced by both inflammation signals and ceramide, could play a major role in the development of insulin resistance in muscle cells. PMID: 26698173
- Classical swine fever virus (CSFV) infection increased the phosphorylation of eukaryotic translation initiation factor (eIF)2alpha and its kinase PKR. The activation of PKR during CSFV infection is beneficial to the virus. PMID: 25899421
- these data indicate a pivotal role for PKR's protein-binding function on the proliferation of pancreatic beta cells through TRAF2/RIP1/NF-kappaB/c-Myc pathways. PMID: 25715336
- The results from this study indicate an important role of RAX/PKR association in regulating PKR activity as well as ethanol neurotoxicity PMID: 25592072
- The G3BP1-Caprin1-PKR complex represents a new mode of PKR activation and is important for antiviral activity of G3BP1 and PKR during infection with mengovirus. PMID: 25784705
- The data support a model in which activating RNAs induce formation of a back-to-back parallel PKR kinase dimer whereas nonactivating RNAs either fail to induce dimerization or produce an alternative, inactive dimer configuration. PMID: 26488609
- Tyrosine phosphorylated EIF2AK2 plays a role in the regulation of insulin induced protein synthesis and in maintaining insulin sensitivity. PMID: 26321373
- PKR expression correlates with inferior survival and shorter remission duration for acute myeloid leukemia patients. PMID: 26202421
- No significant association was determined between the rs2254958 EIF2AK2 polymorphism and the development of IBD, or clinical outcome. PMID: 25607115
- the affinity of PACT-PACT and PACT-PKR interactions is enhanced in dystonia patient lymphoblasts, thereby leading to intensified PKR activation and enhanced cellular death. PMID: 26231208
- Protein levels of PRKR were significantly increased in prefrontal cortex in chronic excessive alcohol use. PMID: 25704249
- Mechanism by which PK2 inhibits the model eIF2alpha kinase human RNA-dependent protein kinase (PKR) as well as native insect eIF2alpha kinases, is reported. PMID: 26216977
- G3BP1, G3BP2 and CAPRIN1 are required for translation of interferon stimulated mRNAs and are targeted by a dengue virus non-coding RNA. PMID: 24992036
- This study demonstrates that two interferon stimulated genes, i.e. PKR and ADAR1 have opposite effects on HTLV replication in vivo. PMID: 25389016
- PKR directly interacts with HIV-1 Tat and phosphorylates the first exon of Tat exclusively at five Ser/Thr residues, which inhibits Tat-mediated provirus transcription. PMID: 25653431
- Authors show that the PXXP domain within G3BP1 is essential for the recruitment of PKR to stress granules, for eIF2alpha phosphorylation driven by PKR, and for nucleating stress granules of normal composition. PMID: 25520508
- Further studies revealed that Andes virus nucleocapsid protein inhibited PKR dimerization, a critical step required for PKR autophosphorylation to attain activity. PMID: 25410857
- SUMO potentiates the inhibition of protein synthesis induced by PKR in response to dsRNA. PMID: 25074923
- Early dsRNA induced transient activation of the cellular dsRNA sensor protein kinase R (PKR), resulting in enhanced production of interferons and cytokines in cells and mice. PMID: 25297997
- Cyclophilin inhibitors reduce phosphorylation of PKR and eIF2alpha during HCV infection to allow for translation of ISG products. PMID: 24786893
顯示更多
收起更多
-
亞細(xì)胞定位:Cytoplasm. Nucleus. Cytoplasm, perinuclear region.
-
蛋白家族:Protein kinase superfamily, Ser/Thr protein kinase family, GCN2 subfamily
-
組織特異性:Highly expressed in thymus, spleen and bone marrow compared to non-hematopoietic tissues such as small intestine, liver, or kidney tissues. Colocalizes with GSK3B and TAU in the Alzheimer disease (AD) brain. Elevated levels seen in breast and colon carcin
-
數(shù)據(jù)庫(kù)鏈接:
Most popular with customers
-
-
YWHAB Recombinant Monoclonal Antibody
Applications: ELISA, WB, IHC, IF, FC
Species Reactivity: Human, Mouse, Rat
-
Phospho-YAP1 (S127) Recombinant Monoclonal Antibody
Applications: ELISA, WB, IHC
Species Reactivity: Human
-
-
-
-
-